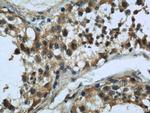
MAD2L1 Antibody in Immunohistochemistry (Paraffin) (IHC (P))
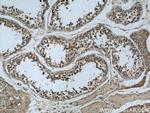
MAD2L1 Antibody in Immunohistochemistry (Paraffin) (IHC (P))

Search
Proteintech
MAD2L1 Monoclonal Antibody (2F5F12)
{{$productOrderCtrl.translations['antibody.pdp.commerceCard.promotion.promotions']}}
{{$productOrderCtrl.translations['antibody.pdp.commerceCard.promotion.viewpromo']}}
{{$productOrderCtrl.translations['antibody.pdp.commerceCard.promotion.promocode']}}: {{promo.promoCode}} {{promo.promoTitle}} {{promo.promoDescription}}. {{$productOrderCtrl.translations['antibody.pdp.commerceCard.promotion.learnmore']}}
产品信息
66014-1-IG
种属反应
宿主/亚型
分类
类型
克隆号
抗原
偶联物
形式
浓度
纯化类型
保存液
内含物
保存条件
运输条件
产品详细信息
Immunogen sequence: SAEIVAEFF SFGINSILYQ RGIYPSETFT RVQKYGLTLL VTTDLELIKY LNNVVEQLKD WLYKCSVQKL VVVISNIESG EVLERWQFDI ECDKTAKDDS APREKSQKAI QDEIRSVIRQ ITATVTFLPL LEVSCSFDLL IYTDKDLVVP EKWEESGPQF ITNSEEVRLR S (16-185 aa encoded by BC000356)
靶标信息
Tight junction proteins (TJPs) belong to a family of membrane-associated guanylate kinase (MAGUK) homologs that are involved in the organization of epithelial and endothelial intercellular junctions. TJPs bind to the cytoplasmic C termini of junctional transmembrane proteins and link them to the actin cytoskeleton.
仅用于科研。不用于诊断过程。未经明确授权不得转售。
篇参考文献 (0)
生物信息学
蛋白别名: HsMAD2; MAD2 (mitotic arrest deficient, yeast, homolog)-like 1; MAD2-like 1; MAD2-like protein 1; MadL1; Mitotic arrest deficient 2-like protein 1; mitotic arrest deficient, yeast, homolog-like 1; Mitotic spindle assembly checkpoint protein MAD2A
基因别名: HSMAD2; MAD2; MAD2L1
UniProt ID: (Human) Q13257
Entrez Gene ID: (Human) 4085